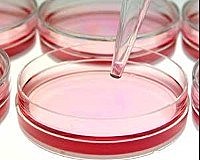
Dulbecco
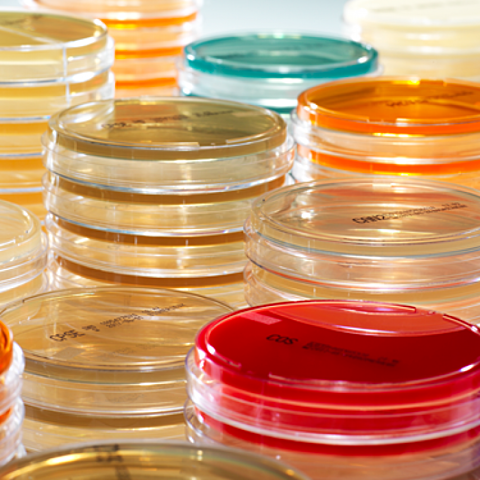
Eagle

-
Crecimiento de fibra nerviosa del embrión de la rana in vitro.
-
Explantación de tejido conectivo de pollo por 2-3 meses
-
Tripsinización y subcultivo de explantes.
-
Subcultivo de líneas celulares fibroblásticas.
-
Diferenciación de los tejidos embrionarios en cultivo de órganos (1925-1926).
-
Cultivo de órganos de huesos largos del pollo.
-
Establecimiento del fibroblasto de ratón de células L; primera línea celular continua.
-
Introducción del uso de antibióticos en el cultivo de tejidos.
-
Clonación de células L.
-
Crecimiento de virus en cultivo celular.
-
Uso de la tripsina para la generación de réplicas de subcultivos.
-
Establecimiento de la primera línea celular humana, HeLa, a partir de un carcinoma cervical.
-
Inhibición por contacto de fibroblastos de la motilidad celular.
-
Desarrollo de medios definidos.
-
Transferencia nuclear.
-
Definición de la vida finita de las células humanas normales.
-
Fusión celular - Hibridación celular somática.
-
Vacunas contra la rabia, paperas y rubéola en fibroblastos de pulmón humano WI-38.
-
Pluripotencia de las células madre embrionarias.
-
Heterocariontes, híbridos hombre-ratón.
-
Líneas celulares linfoblásticas
-
Desarrollo de cabinas de flujo laminar
-
Factores de crecimiento.
-
Hibridomas: Anticuerpos monoclonales.
-
Totipotencia de las células madre embrionarias.
-
Desarrollo de numerosas líneas celulares especializadas.
-
Regulación de la expresión génica.
-
Regulación del ciclo celular: la ciclina.
-
Cultivos cutáneos reconstituidos.
-
Cultivo a escala industrial de células transfectadas para la producción de biofármacos.
-
Cultivo de células madre mesenquimales adultas .
-
Cultivo de células madre embrionarias humanas.
-
Proyecto Genoma Humano
-
Explotación de la ingeniería tisular.
-
Reprogramación de células adultas para que se conviertan en células madre pluripotentes (iPS).
-
Inducción de células iPS mediante reprogramación con ácido valproico.
Looking for a timeline maker?
Create timelines for projects, roadmaps, history, lessons, legal cases, and stories with Timetoast. Timetoast is a timeline maker for work, school, research, and stories.